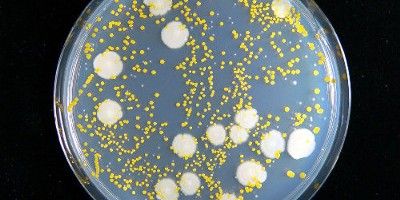
食器のつけ置きがヤバイ 10時間で排水口並みに菌が繁殖 食べたらすぐ洗おう オレ的ゲーム速報 刃

水切りラック食器収納 食器棚 カバー付きキッチン収納 箸立て付き 食器立て 皿立て食器用水切りカゴ キッチン 収納ボックス 台所用品収納 台所 清潔感 家庭用 清潔 衛生的 防塵 防汚 防虫 抗菌 便利大容量 多機能 食器乾燥ボックス (ブルー) 5つ星のうち42 3 ¥2,0 ¥2,0 配送料無料 通常4~5日以内に発送します。ノロウイルスの消毒方法 感染予防の基本は『 手洗い PDF:3KB 』です。 洗い残しのない手洗いを心がけましょう! ※ 手洗いは消毒ではありませんが、手の脂肪等の汚れを落とすことにより、ウイルスを手指から剥がれやすくする効果があります。 親指手洗い:食器点数40点・小物点、水温 ℃。10 Lのお湯(約40 ℃)でつけ置き洗いした後、洗剤を96 mL使用(1本315 mL入り163円(税込))〈日本電機工業会調べ〉して洗い、毎分6 Lで食器1点あたり135秒、小物1点あたり55秒流し湯ですすいだとき、使用水量は約75 L。〈日本電機工業会自主

洗い桶 丸型 直径30cm ステンレス製 アットアクア 洗桶 洗いおけ たらい タライ 桶 おけ オケ つけ置き シンク用品 キッチン用品 食器の通販はau Pay マーケット リビングート
食器 つけ置き 洗剤
食器 つけ置き 洗剤- つけ置きのメリット ・ ドライマークの表示がある衣類もダメージを与えにくい ・ ワイシャツやブラウスなども型崩れしない ・ 生地を傷めずに、汚れを浮かすことが出来る ・ 繊維の奥から汚れを浮かすため、消臭効果も期待できる つけ置き洗いのデメリット折りたたみ ソフト洗い桶 排水機能 折りたたみバケツ 洗いかご 水切りかご つけ置き シンク上調理器具送料無料(一部地域を除く) 1,300 円 送料無料




ほったらかし洗い で 食器洗いに向かう気持ちまでラクになる台所用洗剤 Charmy Magica 酵素 プラス シリーズ新発売 ライオン株式会社のプレスリリース
つけ置き後の変化です。 きれいになりました。 これで食器・マグカップの漂白は完了です。 キッチンハイターの泡状のものを使えば、このように「ひっくり返してつけ置き」をしなくともよいかもしれません。 つけ置き するだけで この時におすすめの布はマイクロファイバークロス。柔らかいし、吸水性もあって、食器を拭くにはもってこいです。 クエン酸水につけおきしたのに、落ちない 上で紹介した水垢をとる方法を試したのに、水垢がまだ残っているというあなた。 まだ落ち込むの洗いおけ 食器 つけ置き キッチン 洗い物 ステンレス製。洗い桶 suiグート D型洗い桶 ゴム足付 小 sui6048 | 洗いおけ 食器 つけ置き キッチン 洗い物 野菜 洗い ふきん洗い ステンレス製 足つき サビない
こびりつきには、食器用洗剤 Magica(マジカ)でつけ置き洗いが効果的です! フライパンの汚れとは フライパンの主な汚れは、サラダオイルなどの 植物の油 はもちろん、魚やお肉の 動物性の脂 です。 『洗い桶に食器をつけておくと、菌がどんどん繁殖するってテレビで見てから、置くのをやめた』 『清潔に使える人なら、問題なくいろいろ活用できるんだろうけど、私はズボラなので置いたらダメだと思っている(笑)』 お手入れが手間だから 『桶を洗うのが、けっこうなストレス』 『 いつものつけおきに 『Magica 酵素+』 を加えて、食事中や食後に食器や調理器具を30分程つけおくだけで、酵素がこびりつき汚れ ※1 を分解します。
食器のつけ置き洗いができる大容量の洗い桶。ハンドル下に穴が開いており、水を流しながら洗い物ができます。 本体にたまった水を直接シンクに流せる水はけ付きです。。洗い桶 タワー 水洗い桶 桶 つけおき洗い つけ置き 水ぬけ穴 ぬけ穴 水止栓付き 水洗い 水切り 水切りラック 台所 ついつい食器をつけ置きして細菌が心配。 そこで、ズボラな私の性格でも簡単に 食器を清潔に保てるように調べてみました! 目次 汚れた食器をつけ置きで3日放置した結果!臭いが取れない時の対処法;スキット まな板つけ置きケース WX0779 SANWA シリコン キッチン用 くるくるたためる 抗菌 コンパクト 錆びない 省スペース 食器 プレート 52x33cm 日本語説明書付き (グレー) 5つ星のうち43 68 ¥1,980 ¥ 1,980 41pt (2%) 貝印 KAI 包丁 スタンド MY FAVORITE 木製 AP05 5つ星のうち42 132 ¥1,953 ¥ 1,953 山崎




日本製とアメリカ製コストコのオキシクリーンの使い方 掃除や漬けおきの写真をブログレポート



Tower タワー 水切りセット 水切りかご 水切りラック つけおき 食器 食器洗い 止水栓 スリム 水切りトレー 山崎実業 Favoritestyle キッチン 雑貨 通販 Yahoo ショッピング
時短 食器洗い シンクに山積みの食器を洗うのは、気が重いですよね。 ベタベタの油汚れや、こびりついた汚れのある食器は、あえてすぐに洗わない「ほったらかし洗い」をしませんか? 洗い桶に食器とぬるま湯と酵素配合の食器用洗剤を入れて30分ほどそのまま置くだけ。 つけている間に洗剤が汚れを分解するので、スルッと落とせるんです。 いいね! 24 Share乾いて汚れがこびりついた食器を夜に水につけて翌日の朝洗っている方もいらっしゃるかと思います。 実はこの長時間のつけ置き洗いは、非常に危険な行為なのです。 長時間のつけ置きでなにが起こっているのか 栄養、〜30℃前後の温度、水分がそろうと、細菌は爆発的に増殖します。 栄養となる食器の汚れ、洗い桶の水、室温と、つけ置きは細菌の増殖に適し 普段使いしている食器に、頑固な汚れやにおいがついてしまったら、 キッチンハイターの登場です! これでつけおきすれば、 汚れも臭いも一網打尽。 でも、陶器ならともかく、 プラスチック製品だとハイターで劣化してしまいそうですよね。 最悪、一部が溶けてしまうかも、と 心配に




Amazon まとめ買い 大容量 チャーミーマジカ 食器用洗剤 酵素プラス フルーティオレンジの香り 詰め替え 大型 0ml 2個 チャーミー マジカ Charmy Magica ドラッグストア



小学校の栄養教諭ですが 学校給食の食器の洗い方のコツを教えてください トップ株式会社
食器を洗うやり方の1つに「つけ置き洗い」というものがありますよね。 つけ置き洗いとは、使用した食器を水に浸けて汚れをふやかし、落としやすくする洗い方です。 昔からある洗い方なので、多くの方が知っているつけ置き洗いですが、きちんとした方法でやらないと危険があります。 食器は毎日使うことになるため、家族の健康に直結することですから、正しいなぜつけ置きが効果的?汚れの性質 洗剤の性質 つけ置き方法 おすすめ洗剤 油汚れには食器用洗剤?掃除の万能アイテム重曹 セスキ炭酸ソーダ レンジフード専用洗剤 最後に レンジフードクリーニングを頼むならカジタク!投稿ナビゲーション セスキ炭酸 用途・つけおき時間の目安 こびりつき汚れの洗浄・除菌・ウイルス除去 ※すべての菌・ウイルスを除去するわけではありません。 鍋 フライパン 食器類:30分~1時間 魚焼きグリル 五徳 レンジの受け皿:2時間~4時間




洗い桶として食器のつけ置き 漂白ができるウォッシュタブ 洗い桶 排水栓付き シンクシンク ウォッシュタブ 抗菌加工 洗桶 洗いおけ たらい タライ 漬け置き つけ置き 皿洗い 食器洗い 洗い物 角型 長方形 四角 Docteurgorj Com




奥さんは中国人 78 つけ置き洗い 実は菌だらけに




洗い桶 排水栓付き シンクシンク ウォッシュタブ 抗菌加工 リビングート ポンパレモール店 ポンパレモール




食器のつけ置き洗いや野菜の洗浄にも便利な洗い桶 洗い




食器用ふきん いつ洗う つけ置き洗いvs洗濯機 多かったのは 主婦305人に調査 Kufura クフラ 小学館公式




楽天市場 Tower 洗い桶 タワー つけ置き 消毒 除菌 漂白 アルコール シンク シンク上 食器洗い おけ ウォッシュタブ バケツ 台所 キッチン お皿 グラス 食器 排水 排水栓 排水口 水切り スクエア 四角 おしゃれ キッチン 雑貨 3591 3592




洗い物マニアの雑記帳 食器の浸け置き洗い1




毎日の食器洗いを時短 私は洗剤水での漬け置き洗いに変更して大幅に時短




ひと晩で雑菌が7万倍にも つけ置き洗いには要注意 Esseonline エッセ オンライン




洗い桶 丸型 直径30cm ステンレス製 アットアクア 洗桶 洗いおけ たらい タライ 桶 おけ オケ つけ置き シンク用品 キッチン用品 食器の通販はau Pay マーケット リビングート



折りたたみ 洗い桶 たらい 丸型 大容量6 0l 畳んでコンパクト収納 食器の付け置き 野菜洗い お掃除 アウトドアなどに 多目的 おけ 桶 洗い桶 33cm 通販 Lineポイント最大0 5 Get Lineショッピング




楽天市場 つけ置き洗い 食器の通販




シンプル使いやすい プラスチック製洗いおけ ウォッシュボウル皿洗い 水洗い つけ置き 漬け置き 漬けおき 漬け置き つけおき 食器 お皿 野菜 キッチングッズ 台所用品 まとめ 洗い桶 ウォッシュタブ 抗菌加工付き キッチン用品 シェリー Scrap2 Org



小学校の栄養教諭ですが 学校給食の食器の洗い方のコツを教えてください トップ株式会社




水切りかご 水切りバスケット Tower タワー 山崎実業 2452 2543 水切りカゴ 水切りラック シンク上 Yamazaki スリム プラスチック 洗い物かご 洗い物カゴ 洗い桶 漬け置き キッチン 収納 食器 皿 乾燥 Antonskc Com




食器の つけ置き洗い で細菌大よろこび 冬こそ気をつけたい食中毒予防のコツ Macaroni




シンプル使いやすい プラスチック製洗いおけ ウォッシュボウル皿洗い 水洗い つけ置き 漬け置き 漬けおき 漬け置き つけおき 食器 お皿 野菜 キッチングッズ 台所用品 まとめ 洗い桶 ウォッシュタブ 抗菌加工付き キッチン用品 シェリー Tempsdefranja Org




ほったらかし洗い で 食器洗いに向かう気持ちまでラクになる台所用洗剤 Charmy Magica 酵素 プラス シリーズ新発売 ライオン株式会社のプレスリリース




洗い桶として食器のつけ置き 漂白ができるウォッシュタブ 洗い桶 排水栓付き シンクシンク ウォッシュタブ 抗菌加工 洗桶 洗いおけ たらい 食器洗い 長方形 信用 四角 漬け置き タライ 39ショップ 洗い物 つけ置き 皿洗い 角型




食器汚れはどう対処する つけ置き洗いの正しいやり方と注意点 マイナビ子育て




食器洗いをするときのng行為4選 食器を放置しすぎるとどうなるの シュフーズ




Amazon Amazon Co Jp 限定 まとめ買い チャーミーマジカ 食器用洗剤 酵素プラス フレッシュピンクベリーの香り 本体2ml 詰め替え 大型 0ml チャーミー マジカ Charmy Magica ドラッグストア



食器のつけ置き洗いがngなわけ 田尻成美のアクアフルライフ



洗い桶 タワー 山崎実業 Tower 洗い桶 大容量 浸け置き つけおき 食器洗い 桶 つけ置き洗い 野菜洗い シンク上 シンク 食器 排水 キッチン 収納 おしゃれ インテリアショップ Roomy 通販 Paypayモール




花王 キュキュット つけおき粉末 新発売




哺乳瓶 ベビー用食器の 除菌と漂白 方法 くすりんの豆知識 V ドラッグ




赤ちゃんの食器 哺乳瓶 ガーゼの消毒に 台所用漂白剤が使える マイカジ Kao



ため洗い を肯定した食器用洗剤 フロッシュ 食器の泡風呂 楽々ため洗い




タワー洗い Vs タメ洗い 食器洗い の やり方 を変えて 楽になる Mammemo



1




楽天市場 洗い桶 Suiグート d型洗い桶 ゴム足付 小 Sui 6048 洗いおけ 食器 つけ置き キッチン 洗い物 野菜 洗い ふきん洗い ステンレス製 足つき サビない 錆びない 丈夫 オンラインショップ びーんず




洗い桶 丸型 直径30cm ステンレス製 アットアクア 洗桶 洗いおけ たらい タライ 桶 おけ オケ つけ置き シンク用品 キッチン用品 食器の通販はau Pay マーケット リビングート




Amazon 水切りかご 折りたたみ Kaoke 水切りラック 食器ラック バスケット ディッシュラック 止水栓付き 洗い桶 カトラリーポケット付き コンパクト つけ置き 洗い かご キッチン 人気 デザイン 水切りラック収納 お掃除用 水切りラック オンライン通販



Q Tbn And9gcswfci E6nfvt3ks Qpnkxqick Wwuikflssplh62w Usqp Cau




楽天市場 P5倍 3日 ステンレス製の小判型洗い桶 足付 送料無料 食器 シンクまわり 洗い桶 ステンレス キッチン キッチン用品 桶 水切り穴付き 野菜 ステンレス製 衛生的 底脚付き シンク周り 下村企販 D Sk 送料無料 調理器具専門店 I Cook




かじはら雑貨店 つけ置き 洗いキャップ 品番 Kjwh かじはら雑貨店 カジハラザッカテン のレディースファッション通販 Shoplist ショップリスト




つけ置き洗い でバイ菌だらけ 菌を増やさないコツ3つ つやプラ つやっときらめく美をプラス 40代からのエイジングを前向きに



1




水切りセット タワー シンク 水切り 水切り ラック




新定番 食器洗いを つけ置き洗い に変えたらストレスが半減した件 わたしの家庭科




水切りかご アクリア 水切りバスケット 排水栓付き 浸け置き リビングート ポンパレモール店 ポンパレモール




かじはら雑貨店 つけ置き 洗いキャップ 品番 Kjwh かじはら雑貨店 カジハラザッカテン のレディースファッション通販 Shoplist ショップリスト




Kohler公式オンラインショップのみでのお取り扱いです コンパクト な 水切りラック は グラス類の ちょっと置き や カトラリー の つけ置き も出来て 便利 Kohler コーラー キッチンシンク用 伸縮 水切りラック カラー ホワイト サイズ W371 448mm X H133 X



トーヤク シブクリーン 食器用浸け置き洗浄剤 250g Jsb01 Webby Shop 通販 Yahoo ショッピング



たためるシリコン洗い桶 漂白剤対応 すべての商品 アイメディア公式webショップ




ほったらかし洗い のすすめ 洗剤 つけ置きで 食器洗いがもっと楽に Lidea リディア By Lion




つけ置き洗いで食器をピカピカに 忙しいママにぴったりの時短テク Teniteo テニテオ




オキシクリーンで食器が洗える オキシ漬けでほったらかすだけ コジカジ




楽天市場 Tower タワー 洗い桶 おしゃれ 角型 水切りかご 大容量 水切りカゴ 水切りラック 食器 収納 水切り ウォッシュタブ スリム コンパクト キッチン 雑貨 ホワイト ブラック Yamazaki 山崎実業 タワーシリーズ 北欧 ホテル 備品 ホテルスタイル ヤマジツ 雑貨




洗い桶 排水栓付き 浸け置き洗い リベラリスタ ウォッシュタ リビングート ポンパレモール店 ポンパレモール




つけ置き の誤解と ため洗い 食器の泡風呂 楽々ため洗い




食器のつけ置き洗いのイラスト素材




食器を洗うときは つけおきor重ねて流水 ラクじゃないと続かない 習慣にしやすい 家事テク やってみた ダ ヴィンチニュース




つけ置き やビニール袋に要注意 見落としがちなキッチンの食中毒対策 この差って何ですか ニュース テレビドガッチ




楽天市場 洗い桶 タワーtower おしゃれ 大容量 シンク キッチン 雑貨 水まわり用品 節水 つけ置き 野菜洗い シンプル モダン モノトーン ホワイト ブラック 山崎実業 Yamazaki 3591 3592 Works インテリアワークス




水切りかご 水切りラック 水切り スリム 水切りバスケット つけおき 食器 キッチン雑貨 キッチン収納 台所 流し台 シンク上 シンプル モの通販はau Pay マーケット エア リゾーム インテリア



シリコン たらい みんな探してる人気モノ シリコン たらい キッチン用品 食器 調理器具




つけ置き やビニール袋に要注意 見落としがちなキッチンの食中毒対策 この差って何ですか ニュース テレビドガッチ




Amazon 茶渋汚れ取り 食器用漬け置き洗浄剤 シブクリーン 250g トーヤク 食器用洗剤




ほったらかし洗い のすすめ 洗剤 つけ置きで 食器洗いがもっと楽に Lidea リディア By Lion




食器を洗うときは つけおきor重ねて流水 ラクじゃないと続かない 習慣にしやすい 家事テク やってみた ダ ヴィンチニュース




洗いおけ 和平フレイズ ゴム足付 食器 和平フレイズ つけ置き 洗い物 個セット Suiグート ゴム足付 洗い桶 大 キッチン ステンレス製 D型洗い桶 Sui 6049 特産品くらぶ




毎日の食器洗いを時短 私は洗剤水での漬け置き洗いに変更して大幅に時短




しつこい茶渋の落とし方 つけ置きからこすり洗いまで9パターンを徹底検証 トクバイニュース




オキシクリーンで食器が洗える オキシ漬けでほったらかすだけ コジカジ

食器のつけ置きがヤバイ 10時間で排水口並みに菌が繁殖 食べたらすぐ洗おう オレ的ゲーム速報 刃




ニトリで見つけた水切りバスケットが 水回りで3回も感動させてくれる理由とは マイ定番スタイル Roomie ルーミー




新発売 キュキュット つけおき粉末 の実力は 頑固なこびりつき汚れで徹底検証 トクバイニュース



Tower タワー 水切りセット 水切りかご 水切りラック つけおき 食器 食器洗い 止水栓 スリム 水切りトレー 山崎実業 Favoritestyle キッチン 雑貨 通販 Yahoo ショッピング




キッチン用 折りたたみ洗い桶 場所を取らないタテ置き 使用後は折りたたんでコンパクトに収納 便利な水抜き栓付き 6 6l 洗い桶 折りたたみ スリム たためる キッチン 洗い 桶 おしゃれ シリコン 折り畳み洗い桶 キッチン用折りたたみ洗い桶 伊勢藤 ソフトタブ キッチン




水切りバスケット 水切りカゴ バスケット 水切りかご 水切り 水切りバスケット 水切りカゴ バスケット 水切りかご 水切りラック 食器 洗い物 シンク 桶 おけ 漂白 つけおき 水切り かご キッチン用品 キッチン 収納 野菜 哺乳瓶 消毒 シンプル コンパクト 水切り




ふきん 洗い桶の人気商品 通販 価格比較 価格 Com




つけ置き洗いで食器をピカピカに 忙しいママにぴったりの時短テク Teniteo テニテオ




節水重視 食器の洗い方 水 時間 洗剤を無駄にしない食器洗い術 家事タウン




洗い桶 丸型 直径30cm ステンレス製 アットアクア 洗桶 洗いおけ たらい タライ 桶 おけ オケ つけ置き シンク用品 キッチン用品 食器の通販はau Pay マーケット リビングート




折りたたみ 無印 洗い桶おすすめ15選 ニトリも紹介 To Buy トゥーバイ



洗い桶 タワー 山崎実業 Tower 洗い桶 大容量 浸け置き つけおき 食器洗い 桶 つけ置き洗い 野菜洗い シンク上 シンク 食器 排水 キッチン 収納 おしゃれ インテリアショップ Roomy 通販 Paypayモール




楽天市場 洗い桶 折りたたみ スリム たためる キッチン 洗い 桶 おしゃれ シリコン 折り畳み洗い桶 キッチン用折りたたみ洗い桶 伊勢藤 ソフトタブ キッチンソフトタブ ホワイト つけ置き洗い 食器 Iseto ポイント2倍 フラリア Fralya フラリア



折りたたみ 洗い桶 たらい 丸型 大容量6 0l 畳んでコンパクト収納 食器の付け置き 野菜洗い お掃除 アウトドアなどに 多目的 おけ 桶 洗い桶 33cm Top1 プライス Paypayモール店 通販 Paypayモール




楽天市場 油汚れ 洗剤 油汚れ落とし 頑固汚れ つけ置き ギトギト 強力 分解 クリーナー シンク つけおき 110番 掃除 換気扇 レンジフード グリル 五徳 コンロ 食器 水筒 茶渋 フライパン 鍋 キッチン 台所 まとめて 汚れ落とし お湯 清掃 生活 応援 支援 うれしい アイテム




キッチン 水切り 食器 調理器具 カラトリー シンク 台所つけおき 桶 新生活 おしゃれ シンプルライフ



1




食器のつけ置き洗いができる大容量の洗い桶 水切りバスケット 洗い桶 角型 タワー Tower 止水栓付き 水切りかご 水切りカゴ 浸け置き ディッシュラック キッチン用品 排水栓付き 山崎実業 注文後の変更キャンセル返品 シンク上 水が流れる 角型洗い桶 シンク内 3980円以上




シンクにたまったぐちゃぐちゃな食器 置き方を変えるだけで洗う気アップ ママスタセレクト




ほったらかし洗い で 食器洗いに向かう気持ちまでラクになる台所用洗剤 Charmy magica 酵素 プラス シリーズ新発売 ニュースリリース ライオン株式会社




おすすめつけ置き洗い用洗剤はコレ 食器を時短で綺麗にしよう お得info




Amazon 食器 水切り かご 折りたたみ バスケット Shinnou ディッシュラック 止水栓付き 排水レール付 洗い桶 カトラリーポケット付き コンパクト つけ置き 洗い かご キッチン 人気 デザイン 水切りラック 水切りラック オンライン通販




食器のつけ置きに 洗い桶 d型 グリーン 容量5 5l フレッシュ Acreditta




衛生面に配慮した食器洗い方法とは Kajily カジリー




Amazon 茶渋汚れ取り 食器用漬け置き洗浄剤 シブクリーン 250g トーヤク 食器用洗剤




ほったらかし洗い のすすめ 洗剤 つけ置きで 食器洗いがもっと楽に Lidea リディア By Lion




食器洗いをするときのng行為4選 食器を放置しすぎるとどうなるの シュフーズ




食器の つけ置き洗い はダメ 菌うじゃうじゃ 排水口並み 汚さ J Cast ニュース 全文表示




食器の つけ置き洗い で細菌大よろこび 冬こそ気をつけたい食中毒予防のコツ Macaroni




楽天市場 Tower タワー 洗い桶 おしゃれ 角型 水切りかご 大容量 水切りカゴ 水切りラック 食器 収納 水切り ウォッシュタブ スリム コンパクト キッチン 雑貨 ホワイト ブラック Yamazaki 山崎実業 タワーシリーズ 北欧 ホテル 備品 ホテルスタイル ヤマジツ 雑貨




ヨドバシ Com 花王 Kao キュキュット 花王 Kao キュキュット キュキュット つけおき粉末 本体 3g 食器用洗剤 通販 全品無料配達



Yohaku ヨハク 余白 セット 水切りバスケット シンク上 コップ 洗い桶 浸け置き マット トレー 伸縮 シンプル 国産 日本製 P1 a にくらす Yahoo 店 通販 Yahoo ショッピング




楽天市場 洗い桶 タワー 水洗い桶 桶 つけおき洗い つけ置き 水ぬけ穴 ぬけ穴 水止栓付き 水洗い 水切り 水切りラック 台所 キッチン 水周り シンク 節水 水はけ キッチン収納 収納 北欧 雑貨 便利 シンプル おしゃれ Tower Swailife




汚れた食器や鍋を水に浸け置きしないできれいにする方法 ライフハッカー 日本版



水切りラック 折りたたみ 排水ノズル付き 360度回転 つけ置き洗い可能 キッチン 台所 食器



0 件のコメント:
コメントを投稿